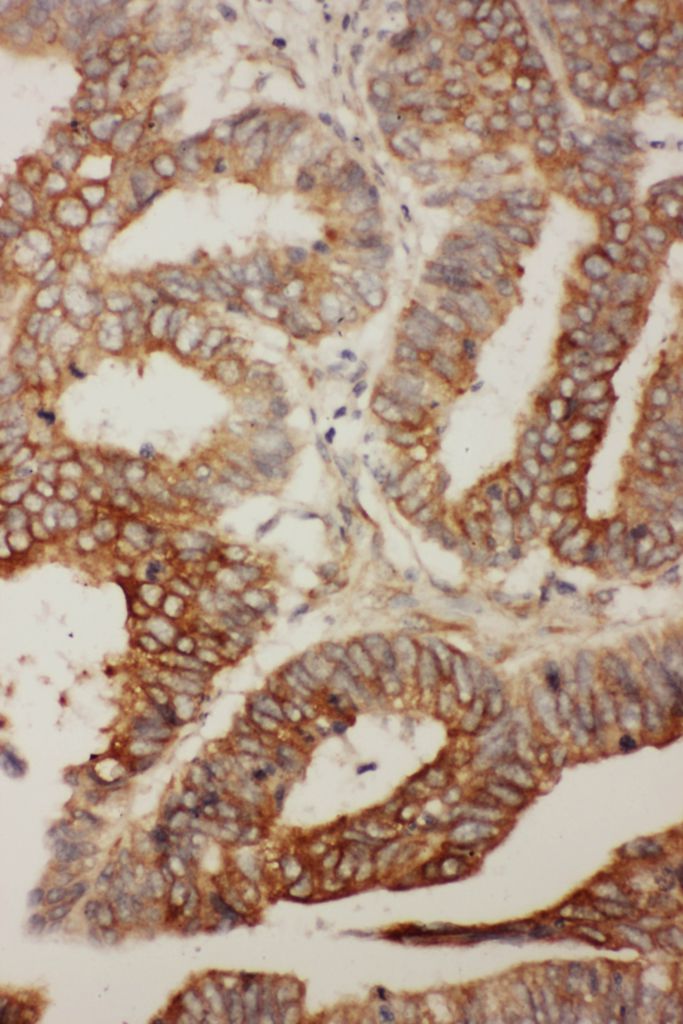

ANTI-BCL2L2 ANTIBODY ,Each
$ 847.06
|
|
Details:
BCL2L2 antibody^ BCL2L2 antibody, Polyclonal, Host: Rabbit, Reactivity: Human, Mouse, RatRabbit IgG, Immunogen: A synthetic peptide corresponding to a sequence in the middle region of human BCL2L2, Application: IHC-P, WB.
Additional Information
| SKU | 23507081 |
|---|---|
| UOM | EACH |
| UNSPSC | 12352203 |
| Manufacturer Part Number | PA1426-1 |
| Product Dimensions | 9X11X11 Inches |
| Product Weight | 0.5 |

